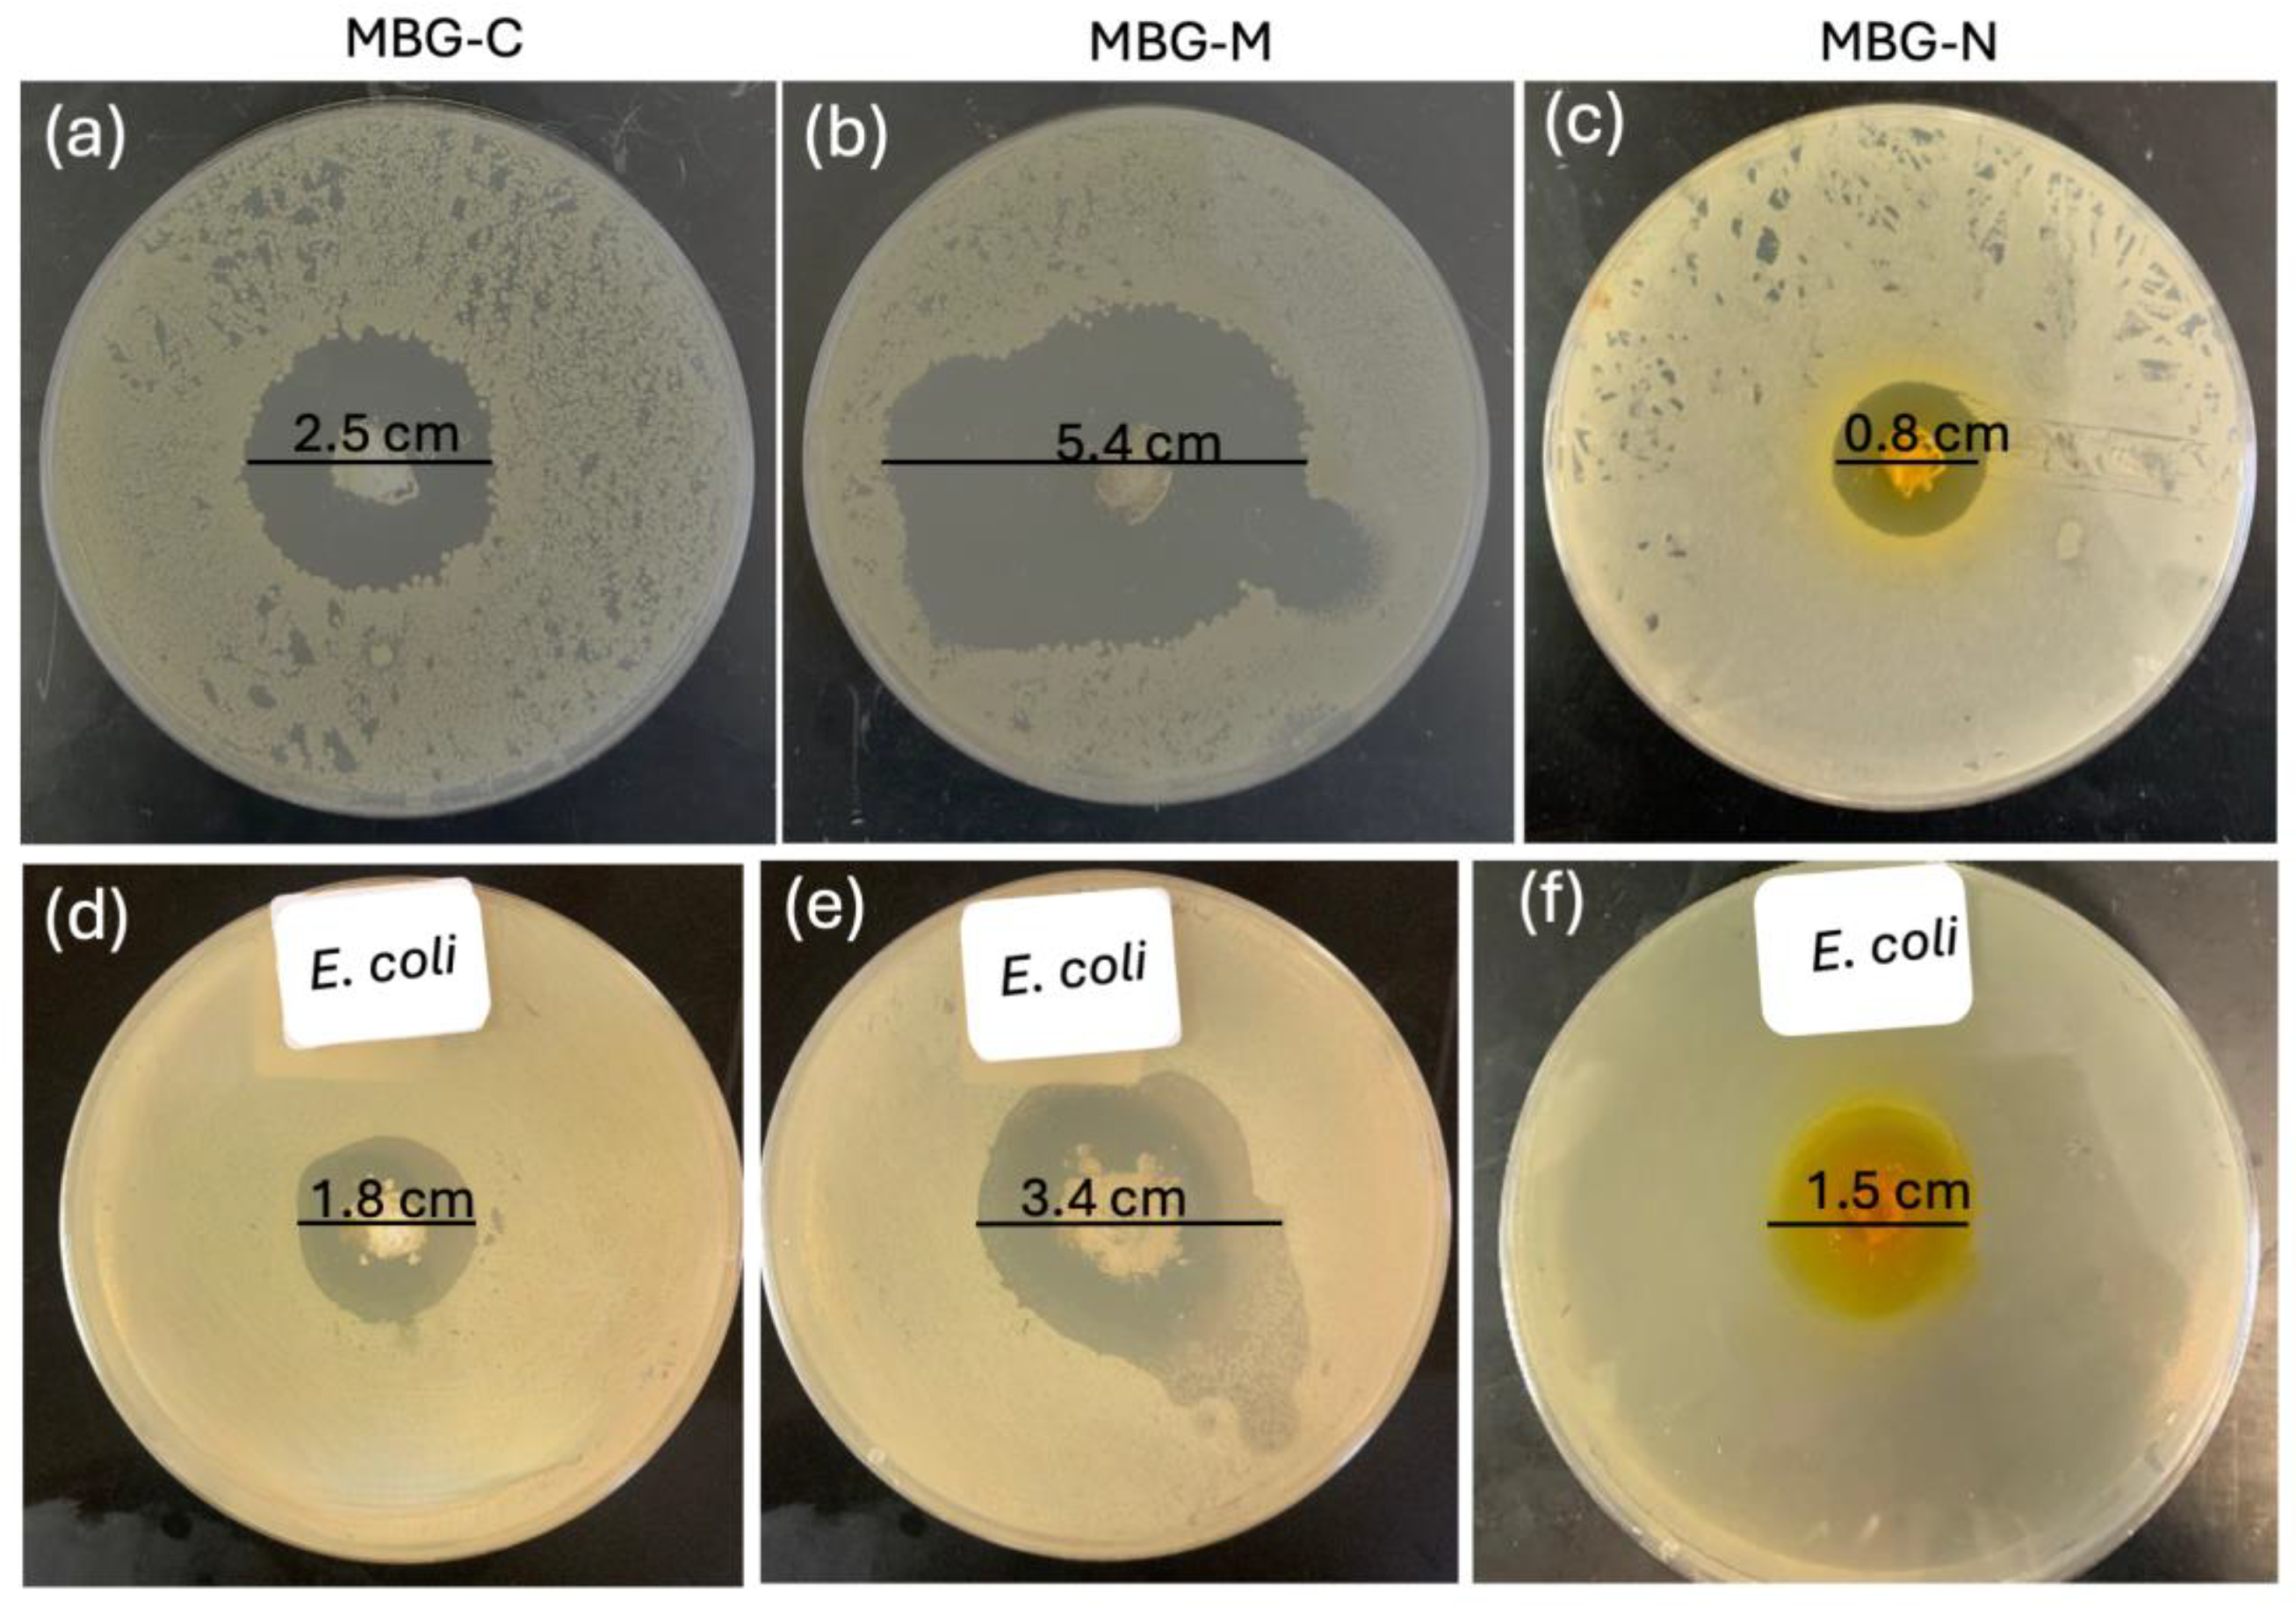
Ijms 26 06524 g010

Greener Synthesis of Eco-Friendly Biodegradable Mesoporous Bioactive Glasses with and Without Thermal Treatment and Its Effects on Drug Delivery and In Vitro Bioactivity
Abstract
1. Introduction
2. Results and Discussion
3. Materials and Methods
3.1. Experimental Procedure for Synthesizing MBG
3.2. Characterization
3.2.1. X-Ray Diffraction
3.2.2. Fourier-Transform Infrared Spectroscopy (FTIR)
3.2.3. Inductively Coupled Plasma Optical Emission Spectrometry (ICP-OES)
3.2.4. Microstructural Characterization
3.2.5. Scanning Electron Microscopy (SEM) and Energy Dispersive X-Ray Spectroscopy (EDX)
3.3. In Vitro Bioactivity
3.4. Drug Loading and In Vitro Release Profile
3.5. Antimicrobial Susceptibility Test
4. Conclusions
Author Contributions
Funding
Institutional Review Board Statement
Informed Consent Statement
Data Availability Statement
Acknowledgments
Conflicts of Interest
Abbreviations
| BET | Braunauer–Emmett–Teller | 
| BJH | Barrett, Joyner, and Halenda | 
| CMC | Critical micelle concentrations | 
| EDX | Energy Dispersive X-ray | 
| FTIR | Fourier-transform infrared spectroscopy | 
| HA | hydroxyapatite | 
| HCl | Hydrochloric acid | 
| ICP-OES | Induced Coupled Optical Emission Spectroscopy Plasma | 
| MBG | Mesoporous bioactive glass | 
| MBG-C | Calcined mesoporous bioactive glass | 
| MBG-N | Mesoporous bioactive glass-NaCl | 
| MBG-M | Mesoporous bioactive glass-Mg(OH)2 | 
| NBO | Non-bridging Oxygens | 
| SBF | Simulated body fluid | 
| SDA | Surface-directing agents | 
| SEM | scanning electron microscopy | 
| XRD | X-Ray Diffraction | 
| ZOI | Zone of inhibition | 
References
- Ciraldo, F.E.; Liverani, L.; Gritsch, L.; Goldmann, W.H.; Boccaccini, A.R. Synthesis and Characterization of Silver-Doped Mesoporous Bioactive Glass and Its Applications in Conjunction with Electrospinning. Materials 2018, 11, 692. [Google Scholar] [CrossRef]
 - Baino, F.; Fiume, E.; Miola, M.; Verné, E. Bioactive sol-gel glasses: Processing, properties, and applications. Int. J. Appl. Ceram. Technol. 2018, 15, 841–860. [Google Scholar] [CrossRef]
 - Sepulveda, P.; Jones, J.R.; Hench, L.L. Bioactive sol-gel foams for tissue repair. J. Biomed. Mater. Res. 2001, 59, 340–348. [Google Scholar] [CrossRef]
 - Cicuéndez, M.; Portole, M.T.; Izquierdo-Barba, I.; Vallet-Regí, M. New Nanocomposite System with Nanocrystalline Apatite Embedded into Mesoporous Bioactive Glass. Chem. Mater. 2012, 24, 1100–1106. [Google Scholar] [CrossRef]
 - Icten, O. The Design of Gold Decorated Iron Borates (Fe3BO6 and FeBO3) for Photothermal Therapy and Boron Carriers. Eur. J. Inorg. Chem. 2021, 2021, 1985–1992. [Google Scholar] [CrossRef]
 - Tigges, S.; Wöhrl, N.; Radev, I.; Hagemann, U.; Heidelmann, M.; Nguyen, T.B.; Gorelkov, S.; Schulz, S.; Lorke, A. One-step synthesis of carbon-supported electrocatalysts. Beilstein J. Nanotechnol. 2020, 11, 1419–1431. [Google Scholar] [CrossRef]
 - Hasnain, J.; Jiang, Y.; Hou, H.; Yan, J.; Athanasopoulou, L.; Forth, J.; Ashby, P.D.; Helms, B.A.; Russell, T.P.; Geissler, P.L. Spontaneous emulsification induced by nanoparticle surfactants. J. Chem. Phys. 2020, 153, 224705. [Google Scholar] [CrossRef]
 - Dai, F.; Zai, J.; Yi, R.; Gordin, M.L.; Sohn, H.; Chen, S.; Wang, D. Bottom-up synthesis of high surface area mesoporous crystalline silicon and evaluation of its hydrogen evolution performance. Nat. Commun. 2014, 5, 3605. [Google Scholar] [CrossRef]
 - Rahman, S.; Mendonca, A.; Alhalawani, A.; Polintan, D.; Clarkin, O.M.; Towler, M.R. The Effect of Calcination Rate on the Structure of Mesoporous Bioactive Glasses. J. Sol-Gel Sci. Technol. 2018, 89, 426–435. [Google Scholar] [CrossRef]
 - Zain, S.K.M.; Sazali, E.S.; Mohd-Noor, F.; Yaacob, S.N.S. Effect of Calcination Temperature on Structure of Mesoporous Borosilicate Bioglass. J. Phys. Conf. Ser. 2021, 1892, 012030. [Google Scholar] [CrossRef]
 - Erasmus, E.P.; Johnson, O.T.; Sigalas, I.; Massera, J. Effects of sintering temperature on crystallization and fabrication of porous bioactive glass scaffolds for bone regeneration. Sci. Rep. 2017, 7, 6046. [Google Scholar] [CrossRef]
 - Mukundan, L.M.; Nirmal, R.; Vaikkath, D.; Nair, P.D. A new synthesis route to high surface area sol gel bioactive glass through alcohol washing. Biomatter 2013, 3, e24288. [Google Scholar] [CrossRef]
 - Kusyak, A.; Poniatovskyi, V.; Oranska, O.; Behunova, D.M.; Melnyk, I.; Dubok, V.; Chornyi, V.; Bur’yanov, O.; Gorbyk, P. Nanostructured sol-gel bioactive glass 60s: In vitro study of bioactivity and antibacterial properties in combination with vancomycin. J. Non-Cryst. Solids 2023, 20, 100200. [Google Scholar] [CrossRef]
 - Yan, X.; Yu, C.; Zhou, X.; Tang, J.; Zhao, D. Highly ordered mesoporous bioactive glasses with superior in vitro bone-forming bioactivities. Angew. Chem. Int. Ed. 2004, 43, 5980–5984. [Google Scholar] [CrossRef]
 - Schumacher, M.; Habibovic, P.; van Rijt, S. Mesoporous Bioactive Glass Composition Effects on Degradation and Bioactivity. Bioact. Mater. 2021, 6, 1921–1931. [Google Scholar] [CrossRef]
 - Almasri, D.; Dahman, Y. Impact of composition and surfactant-templating on mesoporous bioactive glasses structural evolution, bioactivity, and drug delivery property. J. Biomater. Appl. 2025, 39, 1064–1083. [Google Scholar] [CrossRef]
 - Tuan, T.A.; Guseva, E.V.; Tien, N.A.; Dat, H.T.; Vuong, B.X. Simple and Acid-Free Hydrothermal Synthesis of Bioactive Glass 58SiO2-33CaO-9P2O5 (wt%). Crystals 2021, 11, 283. [Google Scholar] [CrossRef]
 - Meechoowas, E.; Tungsanguan, O.; Pamok, C.; Tapasa, K. Investigation of morphology, structure and bioactivity of bioactive glass. Meter. Today 2023, in press. [CrossRef]
 - Shah, A.T.; Ain, Q.; Chaudhry, A.A.; Khan, A.F.; Iqbal, B.; Ahmad, S.; Siddiqi, S.A.; Rehman, I.U. A study of the effect of precursors on physical and biological properties of mesoporous bioactive glass. J. Mater. Sci. 2015, 50, 1794–1804. [Google Scholar] [CrossRef]
 - Hench, L.L. The story of Bioglass®. J. Mater. Sci. Mater. Med. 2006, 17, 967–978. [Google Scholar] [CrossRef]
 - Jones, J.R. Review of bioactive glass: From Hench to Hybrids. Acta Biomater. 2013, 9, 4457–4486. [Google Scholar] [CrossRef]
 - Hench, L.L.; Jones, J.R. Bioactive Glasses: Frontiers and Challenges. Front. Bioeng. Biotechnol. 2015, 3, 194. [Google Scholar] [CrossRef]
 - Anand, A.; Lalzawmliana, V.; Kumar, V.; Das, P.; Devi, K.B.; Maji, A.K.; Kundu, B.; Roy, M.; Nandi, S.K. Preparation and in vivo biocompatibility studies of different mesoporous bioactive glasses. J. Mech. Behav. Biomed. Mater. 2019, 89, 89–98. [Google Scholar] [CrossRef]
 - Ranga, N.; Poonia, E.; Jakhar, S.; Sharma, A.K.; Kumar, A.; Devi, S.; Duhan, S. Enhanced antimicrobial properties of bioactive glass using strontium and silver oxide nanocomposites. J. Asian Ceram. Soc. 2019, 7, 75–81. [Google Scholar] [CrossRef]
 - Almasri, D.; Dahman, Y. Bioactive Glass Preloaded with Antibiotics for Delivery of Long-Term Localized Drug Release Exhibiting Inherent Antimicrobial Activity. Appl. Sci. 2025, 15, 5363. [Google Scholar] [CrossRef]
 - Bui, X.V.; Dang, H.T. Bioactive glass 58S prepared using an innovation sol-gel process. Process. Appl. Ceram. 2019, 13, 98–108. [Google Scholar] [CrossRef]
 - England, C.G.; Miller, M.C.; Kuttan, A.; Trent, J.O.; Frieboes, H.B. Release kinetics of paclitaxel and cisplatin from two and three layered gold nanoparticles. Eur. J. Pharm. Biopharm. 2015, 92, 120–129. [Google Scholar] [CrossRef]
 - Notingher, I.; Jones, J.R.; Verrier, S.; Bisson, I.; Embanga, P.; Edwards, P.; Polak, J.M.; Hench, L.L. Application of FTIR and Raman spectroscopy to characterisation of bioactive materials and living cells. Spectroscopy 2003, 17, 275–288. [Google Scholar] [CrossRef]
 - Yan, X.X.; Deng, H.X.; Huang, X.H.; Lu, G.Q.; Qiao, S.Z.; Zhao, D.Y.; Yu, C.Z. Mesoporous bioactive glasses. I. Synthesis and structural characterization. J. Non-Cryst. Solids 2005, 351, 3209–3217. [Google Scholar] [CrossRef]
 - Wu, C.; Chang, J.; Xiao, Y. Advanced Bioactive Inorganic Materials for Bone Regeneration and Drug Delivery; CRC Press: Boca Raton, FL, USA, 2013; pp. 1–24. [Google Scholar]
 - Bayramov, D.F.; Neff, J.A. Beyond conventional antibiotics—New directions for combination products to combat biofilm. Adv. Drug Deliv. Rev. 2017, 112, 48–60. [Google Scholar] [CrossRef]
 - Chen, J.; Zeng, L.; Chen, X.; Liao, T.; Zheng, J. Preparation and characterization of bioactive glass tablets and evaluation of bioactivity and cytotoxicity in vitro. Bioact. Mater. 2018, 3, 314–321. [Google Scholar] [CrossRef]
 - Salètes, M.; Vartin, M.; Mocquot, C.; Chevalier, C.; Grosgogeat, B.; Colon, P.; Attik, N. Mesoporous Bioactive Glasses Cytocompatibility Assessment: A Review of In Vitro Studies. Biomimetics 2021, 6, 9. [Google Scholar] [CrossRef]
 - Kokubo, T.; Takadama, H. How useful is SBF in predicting in vivo bone bioactivity? Biomaterials 2006, 27, 2006. [Google Scholar] [CrossRef]
 - Rabiee, S.M.; Nazparvar, N.; Azizian, M.; Vashaee, D.; Tayebi, L. Effect of ion substitution on properties of bioactive glasses: A review. Ceram. Int. 2015, 41, 7241–7251. [Google Scholar] [CrossRef]
 - Wu, C.; Fan, W.; Zhu, Y.; Gelinsky, M.; Chang, J.; Cuniberti, G.; Albrecht, V.; Friis, T.; Xiao, Y. Multifunctional magnetic mesoporous bioactive glass scaffolds with a hierarchical pore structure. Acta Biomater. 2011, 7, 3563–3572. [Google Scholar] [CrossRef]
 - Adams, L.A.; Essien, E.R.; Adesalu, T.A.; Julius, M.L. Bioactive Glass 45S5 from Diatom Biosilica. J. Sci. Adv. Mater. Devices 2017, 2, 476–482. [Google Scholar] [CrossRef]
 - Sooksaen, P.; Chaithep, K.; Saliwong, T.; Duangart, T. Apatite-wollastonite bioactive glass-ceramic scaffolds for hard tissue engineering. Adv. Mater. Res. 2012, 506, 146–149. [Google Scholar] [CrossRef]
 - Kirsten, A.; Hausmann, A.; Weber, M.; Fischer, J.; Fischer, H. Bioactive and thermally compatible glass coating on zirconia dental implants. J. Dent. Res. 2014, 94, 297–303. [Google Scholar] [CrossRef]
 - Ambroz, F.; Macdonald, T.J.; Martis, V.; Parkin, I.P. Evaluation of the BET Theory for the Characterization of Meso and Microporous Mofs. Small Methods 2018, 2, 1800173. [Google Scholar] [CrossRef]
 - Bai, N.; Chen, W.; Luo, L.; Tong, W.; Wen, C.; Zhan, X.; Sa, B. Effect of B2O3 on the structural and in vitro biological assessment of mesoporous bioactive glass nanospheres. J. Am. Ceram. Soc. 2021, 104, 3058–3072. [Google Scholar] [CrossRef]
 - Dang, T.H.; Bui, T.H.; Guseva, E.V.; Ta, A.T.; Nguyen, A.T.; Hoang, T.T.H.; Bui, X.V. Characterization of Bioactive Glass Synthesized by Sol-Gel Process in Hot Water. Crystals 2020, 10, 529. [Google Scholar] [CrossRef]
 - Xia, W.; Chang, J. Well-ordered mesoporous bioactive glasses (MBG): A promising bioactive drug delivery system. J. Control. Release 2006, 110, 522–530. [Google Scholar] [CrossRef]
 - Lei, B.; Chen, X.; Wang, Y.; Zhao, N.; Du, C.; Zhang, L. Acetic acid derived mesoporous bioactive glasses with an enhanced in vitro bioactivity. J. Non-Cryst. Solids 2009, 355, 2583–2587. [Google Scholar] [CrossRef]
 - de Souza, L.; Lopez, J.; Encarnação, D.; Mazali, I.O.; Martin, R.A.; Camilli, J.A.; Bertran, C.A. Comprehensive in vitro and in vivo studies of novel melt-derived Nb-substituted 45S5 bioglass reveal its enhanced bioactive properties for bone healing. Sci. Rep. 2018, 8, 12808. [Google Scholar] [CrossRef]
 - Vallet-Regí, M.; Schüth, F.; Lozano, D.; Colilla, M.; Manzano, M. Engineering mesoporous silica nanoparticles for drug delivery: Where are we after two decades? Chem. Soc. Rev. 2022, 51, 5365–5451. [Google Scholar] [CrossRef]
 - Alenezi, A. The Antibacterial Performance of Implant Coating Made of Vancomycin-Loaded Polymer Material: An In Vitro Study. Surfaces 2023, 6, 304–315. [Google Scholar] [CrossRef]
 - Kargozar, S.; Montazerian, M.; Hamzehlou, S.; Kim, H.-W.; Baino, F. Mesoporous bioactive glasses: Promising platforms for antibacterial strategies. Acta Biomater. 2018, 81, 1–19. [Google Scholar] [CrossRef]
 - Siepmann, J.; Peppas, N.A. Higuchi equation: Derivation, applications, use and misuse. Int. J. Pharm. 2011, 418, 6–12. [Google Scholar] [CrossRef]
 - Higuchi, T. Mechanism of sustained-action medication theoretical analysis of rate of release of solid drugs dispersed in solid matrices. J. Pharm. Sci. 1963, 52, 1145–1149. [Google Scholar] [CrossRef]
 - Izquierdo-Barba, I.; Vallet-Regí, M. Mesoporous Bioactive Glasses: Relevance of Their Porous Structure Compared to That of Classical Bioglasses. Biomed. Glas. 2015, 1, 140–150. [Google Scholar] [CrossRef]
 - Koo, H.; Allan, R.N.; Howlin, R.P.; Stoodley, P.; Hall-Stoodley, L. Targeting microbial biofilms: Current and prospective therapeutic strategies. Nat. Rev. Microbiol. 2017, 15, 740–755. [Google Scholar] [CrossRef] [PubMed]
 - Lebeaux, D.; Ghigo, J.M.; Beloin, C. Biofilm-Related Infections: Bridging the Gap between Clinical Management and Fundamental Aspects of Recalcitrance toward Antibiotics. Microbiol. Mol. Biol. Rev. 2014, 78, 510–543. [Google Scholar] [CrossRef]
 - Huang, X.; Brazel, C.S. On the importance and mechanisms of burst release in matrix-controlled drug delivery systems. J. Control. Release 2001, 73, 121–136. [Google Scholar] [CrossRef]
 - Fredenberg, S.; Wahlgren, M.; Reslow, M.; Axelsson, A. The mechanisms of drug release in poly(lactic-co-glycolic acid)-based drug delivery systems—A review. Int. J. Pharm. 2011, 415, 34–52. [Google Scholar] [CrossRef]
 - Korsmeyer, R.W.; Gurny, R.; Doelker, E.; Buri, P.; Peppas, N.A. Mechanisms of solute release from porous hydrophilic polymers. Int. J. Pharm. 1983, 15, 25–35. [Google Scholar] [CrossRef]
 - Ritger, P.L.; Peppas, N.A. A simple equation for description of solute release II. Fickian and anomalous release from swellable devices. J. Control. Release 1987, 5, 37–42. [Google Scholar] [CrossRef]
 - Zhu, Y.; Kaskel, S. Comparison of the in vitro bioactivity and drug release property of mesoporous bioactive glasses (MBGs) and bioactive glasses (BGs) granules. Microporous Mesoporous Mater. 2009, 118, 176–182. [Google Scholar] [CrossRef]
 - Luz, G.M.; Mano, J.F. Preparation and characterization of bioactive glass nanoparticles prepared by sol–gel for biomedical applications. Nanotechnology 2011, 22, 494014. [Google Scholar] [CrossRef]
 - Waaijers, S.L.; Kong, D.; Hendriks, H.S.; de Wit, C.A.; Cousins, I.T.; Westerink, R.H.; Leonards, P.E.; Kraak, M.H.; Admiraal, W.; de Voogt, P.; et al. Persistence, Bioaccumulation, and Toxicity of Halogen-Free Flame Retardants. In Reviews of Environmental Contamination and Toxicology; Whitacre, D., Ed.; Springer: New York, NY, USA, 2013; Volume 222, pp. 1–71. [Google Scholar]
 - Cannio, M.; Bellucci, D.; Roether, J.A.; Boccaccini, D.N.; Cannillo, V. Bioactive Glass Applications: A Literature Review of Human Clinical Trials. Materials 2021, 14, 5440. [Google Scholar] [CrossRef]
 - Zhang, J.; Qu, F.Y.; Lin, H.M.; Wu, X.; Jiang, J.J. Mesoporous bioactive glass: Ideal material for higher uptake and well sustained release of ibuprofen. Mater. Res. Innov. 2012, 16, 230–235. [Google Scholar] [CrossRef]
 - El-Kady, A.M.; Ahmed, M.M.; El-Hady, B.M.A.; Ali, A.F.; Ibrahim, A.M. Optimization of ciprofloxacin release kinetics of novel Nano-bioactive glasses: Effect of glass modifier content on drug loading and release mechanism. J. Non-Cryst. Solids 2019, 521, 119471. [Google Scholar] [CrossRef]
 - Jain, P.S.; Chaudhari, A.J.; Patel, S.A.; Patel, Z.N.; Patel, D.T. Development and validation of the UV-spectrophotometric method for determination of terbinafine hydrochloride in bulk and in formulation. Pharm. Methods 2011, 2, 198–202. [Google Scholar] [CrossRef]
 - Zarghami, V.; Ghorbani, M.; Bagheri, K.P.; Shokrgozar, M.A. In vitro bactericidal and drug release properties of vancomycin-amino surface functionalized bioactive glass nanoparticles. Mater. Chem. Phys. 2020, 241, 122423. [Google Scholar] [CrossRef]
 - Bruschi, M.L. Modify the Drug Release from Pharmaceutical Systems; Woodhead Publishing: Cambridge, UK, 2015. [Google Scholar]
 - Dash, S.; Murthy, P.N.; Nath, L.; Chowdhury, P. Kinetic modeling on drug release from controlled drug delivery systems. Acta Pol. Pharm. 2010, 67, 217–223. [Google Scholar]
 - Andrews, J.M. BSAC standardized disc susceptibility testing method (version 4). J. Antimicrob. Chemother. 2005, 56, 60–76. [Google Scholar] [CrossRef]

| MBG | Surface Area (m2/g) | Pore Volume (cm3/g) | Pore Size (nm) | 
|---|---|---|---|
| MBG-C | 201.41 | 0.33 | 6.56 | 
| MBG-M before washing | 74.37 | 0.14 | 3.75 | 
| MBG-M after washing | 426.91 | 0.36 | 7.41 | 
| MBG-N before washing | 46.59 | 0.14 | 5.75 | 
| MBG-N after washing | 174.24 | 0.26 | 5.96 | 
| MBG | Loading Efficiency (%) | 
|---|---|
| MBG-C | 61 ± 5.12 | 
| MBG-M | 88 ± 1.76 | 
| MBG-N | 26 ± 3.12 | 
Disclaimer/Publisher’s Note: The statements, opinions and data contained in all publications are solely those of the individual author(s) and contributor(s) and not of MDPI and/or the editor(s). MDPI and/or the editor(s) disclaim responsibility for any injury to people or property resulting from any ideas, methods, instructions or products referred to in the content.  | 
© 2025 by the authors. Licensee MDPI, Basel, Switzerland. This article is an open access article distributed under the terms and conditions of the Creative Commons Attribution (CC BY) license (https://creativecommons.org/licenses/by/4.0/).
Share and Cite
Almasri, D.; Dahman, Y. Greener Synthesis of Eco-Friendly Biodegradable Mesoporous Bioactive Glasses with and Without Thermal Treatment and Its Effects on Drug Delivery and In Vitro Bioactivity. Int. J. Mol. Sci. 2025, 26, 6524. https://doi.org/10.3390/ijms26136524
Almasri D, Dahman Y. Greener Synthesis of Eco-Friendly Biodegradable Mesoporous Bioactive Glasses with and Without Thermal Treatment and Its Effects on Drug Delivery and In Vitro Bioactivity. International Journal of Molecular Sciences. 2025; 26(13):6524. https://doi.org/10.3390/ijms26136524
Chicago/Turabian StyleAlmasri, Dana, and Yaser Dahman. 2025. "Greener Synthesis of Eco-Friendly Biodegradable Mesoporous Bioactive Glasses with and Without Thermal Treatment and Its Effects on Drug Delivery and In Vitro Bioactivity" International Journal of Molecular Sciences 26, no. 13: 6524. https://doi.org/10.3390/ijms26136524
APA StyleAlmasri, D., & Dahman, Y. (2025). Greener Synthesis of Eco-Friendly Biodegradable Mesoporous Bioactive Glasses with and Without Thermal Treatment and Its Effects on Drug Delivery and In Vitro Bioactivity. International Journal of Molecular Sciences, 26(13), 6524. https://doi.org/10.3390/ijms26136524
        
